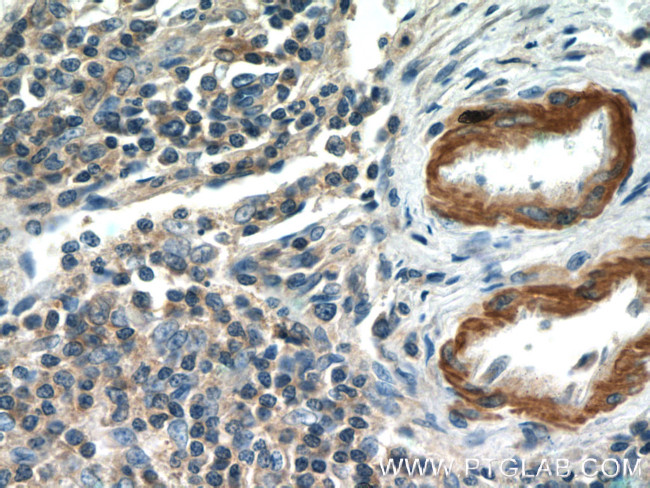
MGP Antibody in Immunohistochemistry (Paraffin) (IHC (P))
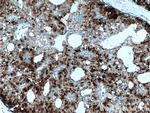
MGP Antibody in Immunohistochemistry (Paraffin) (IHC (P))

Search
Proteintech
MGP Polyclonal Antibody
{{$productOrderCtrl.translations['antibody.pdp.commerceCard.promotion.promotions']}}
{{$productOrderCtrl.translations['antibody.pdp.commerceCard.promotion.viewpromo']}}
{{$productOrderCtrl.translations['antibody.pdp.commerceCard.promotion.promocode']}}: {{promo.promoCode}} {{promo.promoTitle}} {{promo.promoDescription}}. {{$productOrderCtrl.translations['antibody.pdp.commerceCard.promotion.learnmore']}}
产品信息
10734-1-AP
种属反应
已发表种属
宿主/亚型
分类
类型
抗原
偶联物
形式
浓度
规格
纯化类型
保存液
内含物
保存条件
运输条件
产品详细信息
Immunogen sequence: MKSLILLAI LAALAVVTLC YESHESMESY ELNPFINRRN ANTFISPQQR WRAKVQERIR ERSKPVHELN REACDDYRLC ERYAMVYGYN AAYNRYFRKR RGAK (1-103 aa encoded by BC005272)
靶标信息
MGP is associates with the organic matrix of bone and cartilage. MGP is thought to act as an inhibitor of bone formation.
仅用于科研。不用于诊断过程。未经明确授权不得转售。
生物信息学
蛋白别名: Cell growth-inhibiting gene 36 protein; MATRIX; matrix gamma-carboxyglutamate (gla) protein; Matrix Gla protein; MGP; unnamed protein product
基因别名: GIG36; MGLAP; MGP; NTI
UniProt ID: (Human) P08493, (Mouse) P19788
Entrez Gene ID: (Human) 4256, (Mouse) 17313